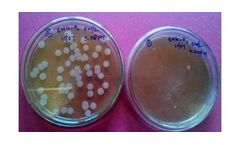
Slivacide - Biocides

- Home
- Equipment
Refine by
Slivacide Environmental Equipment & Supplies
1 equipment items found
by:Terawet Green Technologies, Inc. (TGT) based inSan Diego, CALIFORNIA (USA)
Silv-Clean is specially developed to inhibit the growth of pathogens on any surface including harvested crops. Silv-Clean does not contain VOCs or harmful or ozone depleting chemicals. Silv-Clean is specially developed to eliminate offensive hospital odors on contact without masking them with fragrances.� It will effectively cleanse the air of offensive odors and complement existing ventilation ...